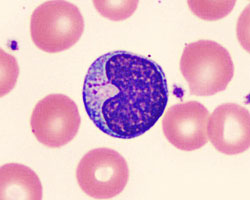

Solving the Genome Puzzle
Putting together a puzzle can be fun and challenging. To put together a jigsaw puzzle with 100 pieces, it can help to start with the corner pieces and look at the picture on the box. If you concentrate and put the pieces in, one at a time, you can slowly build the puzzle. Harder puzzles, with 1,000 pieces or more, may take a few hours or even a few days.

Now imagine putting together a huge puzzle that has over three billion pieces. How long might that take? To make things harder, this puzzle has no corner pieces but is just one long line of code. To make things even more difficult, there is no picture on the box. The only clues are that some of the puzzle pieces overlap. By matching the ends, the puzzle can be made longer a little bit at a time.
That was what it was like to sequence the first human genome. Rather than spending a few days solving the puzzle, scientists spent 13 years putting together all of the pieces. That is a long time. Today, with faster and better computers, sequencing a genome takes a lot less time. Setting out to sequence a genome can be a big challenge and take many months to complete. But how do scientists do it?
First scientists need to collect some DNA. DNA can be found in almost every cell in the body of any living organism. It can be found in a cell in an animal’s cheek, spit, hair, or skin.
Collecting DNA
Let’s use the Gila monster as an example animal. If a scientist wants to sequence the genome of a Gila monster, they can collect DNA by drawing some Gila monster blood (unlike people, reptiles have DNA in their blood cells). The second step is to separate the DNA from the blood cells. This may sound complicated, but it can be done using ingredients that can be found in a kitchen. By using salt, detergent, and rubbing alcohol, you can purify the DNA from a banana. In a similar way, scientists can purify the DNA from animal cells.
To get the DNA out of the cells, scientists have to break through the membrane of the cell and then through the membrane of the nucleus. If you were extracting DNA from a banana, this is where the detergent comes in.
In the kitchen, detergent cleans dishes by attaching itself to grease and fat and pulling it into the water, away from the dishes. Then the water and the grease can be rinsed down the drain. In cells, the detergent does the same thing. It attaches to the fats that hold the membrane together and pulls them away, opening the membrane and letting the DNA out.
Next, by mixing in salt, the DNA clumps together in a group, making it easier to find. The last step in DNA extraction is to mix in the alcohol and water. The DNA will rise to the layer between the water and the alcohol, or might float around in the alcohol. What does it look like? Just like a big pile of snot.
One step scientists take that you might not do in looking at banana DNA is to cut the long strands of DNA into smaller pieces. Scientists use special chemical scissors, called enzymes, to slice and dice DNA. They cut different batches of the same DNA in different spots, so that when they bring them together, some of the DNA strands will overlap.
Decoding DNA
Once scientists have purified and collected the DNA, they copy it to make enough for their experiments. They use a special machine, called a DNA sequencer, to read all of the DNA letters. The newest, brightest and shiniest DNA sequencing machines can read about 150,000 DNA letters at a time.

The machine will translate the chemical code from the DNA into rows of the letters A, C, T, and G. Each of these rows of letters is a piece of the puzzle. Each puzzle piece is a portion of DNA code that is about 150,000 DNA letters long. The completed puzzle could be billions of letters long.
Once all the puzzle pieces are sequenced, it’s time to build the puzzle. By sequencing pieces that overlap, the scientists can use the overlapping DNA letters to figure out where a piece should sit. The first time a genome is sequenced for a living organism, scientists need to sequence much more DNA (in order to find all the overlapping pieces of the puzzle), and use a lot more computer time to analyze the possible combinations of putting the puzzle together.
The first genome created for a species is called a reference genome, which is like creating the picture on the front of the puzzle box. Every Gila monster genome after the first one will be much easier to put together because it will look similar to the reference genome.
Read more about: What's a Genome?
Bibliographic details:
- Article: Solving the Genome Puzzle
- Author(s): Dr. Biology
- Publisher: Arizona State University School of Life Sciences Ask A Biologist
- Site name: ASU - Ask A Biologist
- Date published: 25 Apr, 2016
- Date accessed:
- Link: https://aabws2-asufactory4.acquia.asu.edu/sequencing-genomes
APA Style
Dr. Biology. (Mon, 04/25/2016 - 19:39). Solving the Genome Puzzle. ASU - Ask A Biologist. Retrieved from https://aabws2-asufactory4.acquia.asu.edu/sequencing-genomes
Chicago Manual of Style
Dr. Biology. "Solving the Genome Puzzle". ASU - Ask A Biologist. 25 Apr 2016. https://aabws2-asufactory4.acquia.asu.edu/sequencing-genomes
MLA 2017 Style
Dr. Biology. "Solving the Genome Puzzle". ASU - Ask A Biologist. 25 Apr 2016. ASU - Ask A Biologist, Web. https://aabws2-asufactory4.acquia.asu.edu/sequencing-genomes
It can be difficult to look at lines and lines of four letters, so there are other ways of representing the genetic code. This way was developed by Gregory Podgorniak.
Be Part of
Ask A Biologist
By volunteering, or simply sending us feedback on the site. Scientists, teachers, writers, illustrators, and translators are all important to the program. If you are interested in helping with the website we have a Volunteers page to get the process started.
